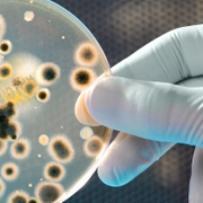
Profile picture

Taha Menasria
Habilitation
-
Associate ProfessorPrimaryUniversity of Batna 2Batna, Algeria
-
ResearcherUniversity of TébessaTébessa, Algeria
